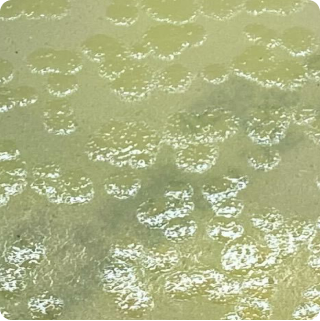

Pseudomonas aeruginosa - Plate
PSEUD
|
Turnaround Time:
5 - 7 days
|

Method Description
Pseudomonas aeruginosa is an opportunistic pathogen that can cause serious infections, particularly in immunocompromised individuals, and is commonly found in water and moist environments. Testing is important for products that may be consumed by vulnerable populations because P. aeruginosa can survive in low-nutrient conditions and resist many disinfectants. The analysis uses selective media that inhibits other bacteria while allowing P. aeruginosa to grow and produce characteristic pigments.
Analyte List
Technical Data Sheet
Method Name
Detection of Presumptive Pseudomonas aeruginosa
Method Code
LAB-TM-088
Equipment Type
Culture Media - Plate
Equipment Details
Cetrimide Agar
Method Reference
USP <62> - Vendor Modified, USP <1223>
Reportable Unit
Sample Size Requirements
Available for
Food, Non-Sterile Pharmaceutical Products, Dietary Supplements, Coffee
Additional Information
Unavailable for
*Prices and offerings are subject to change without notice.